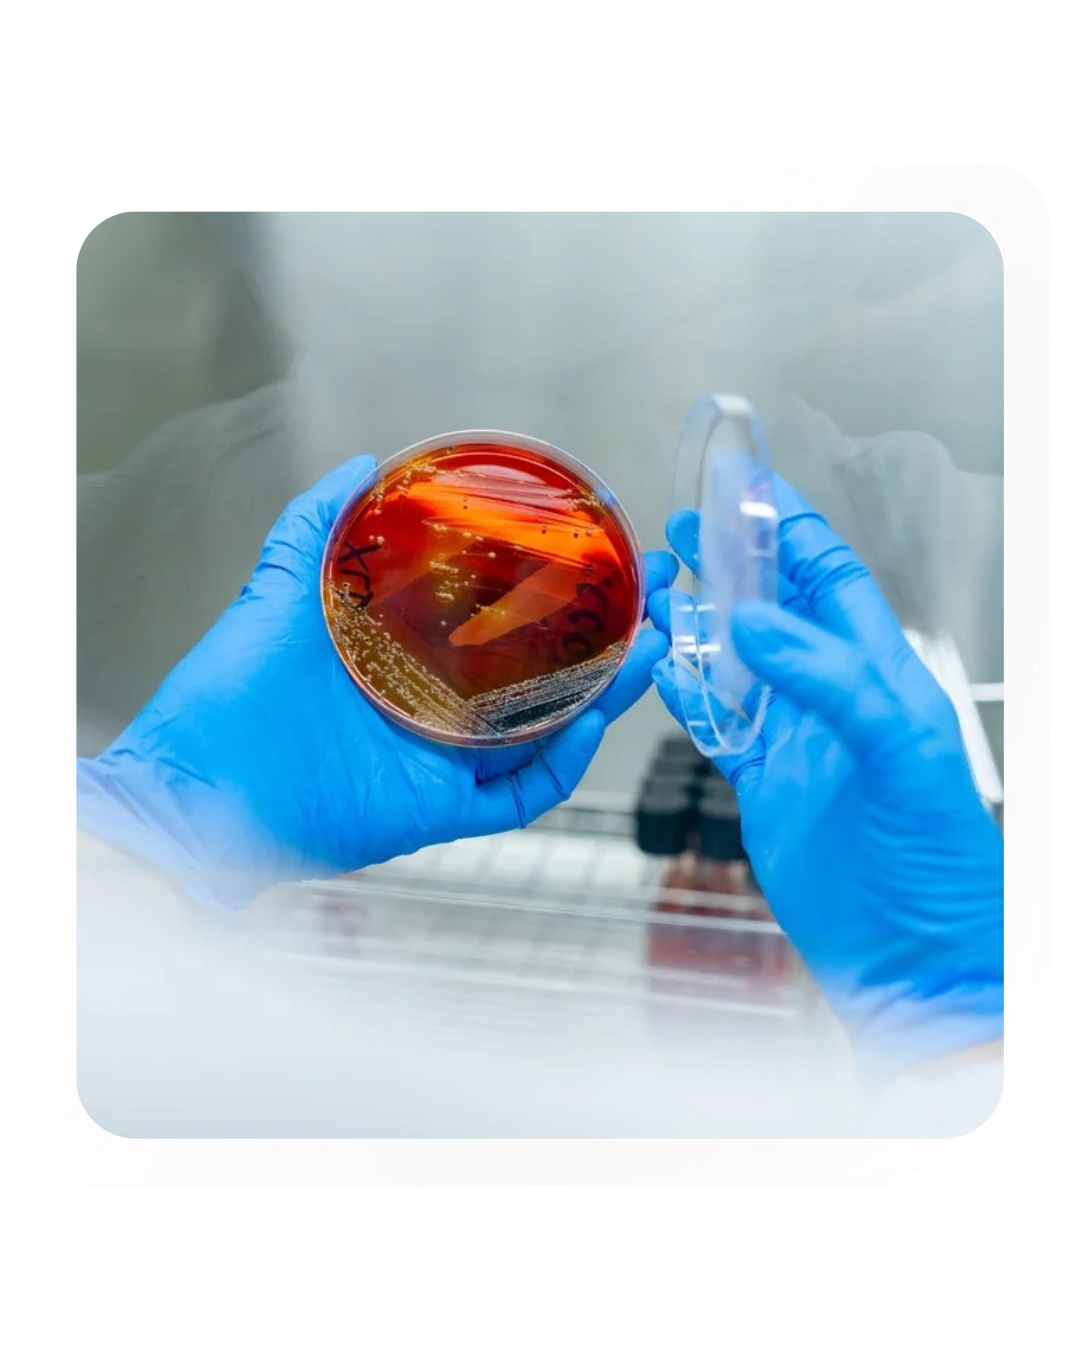
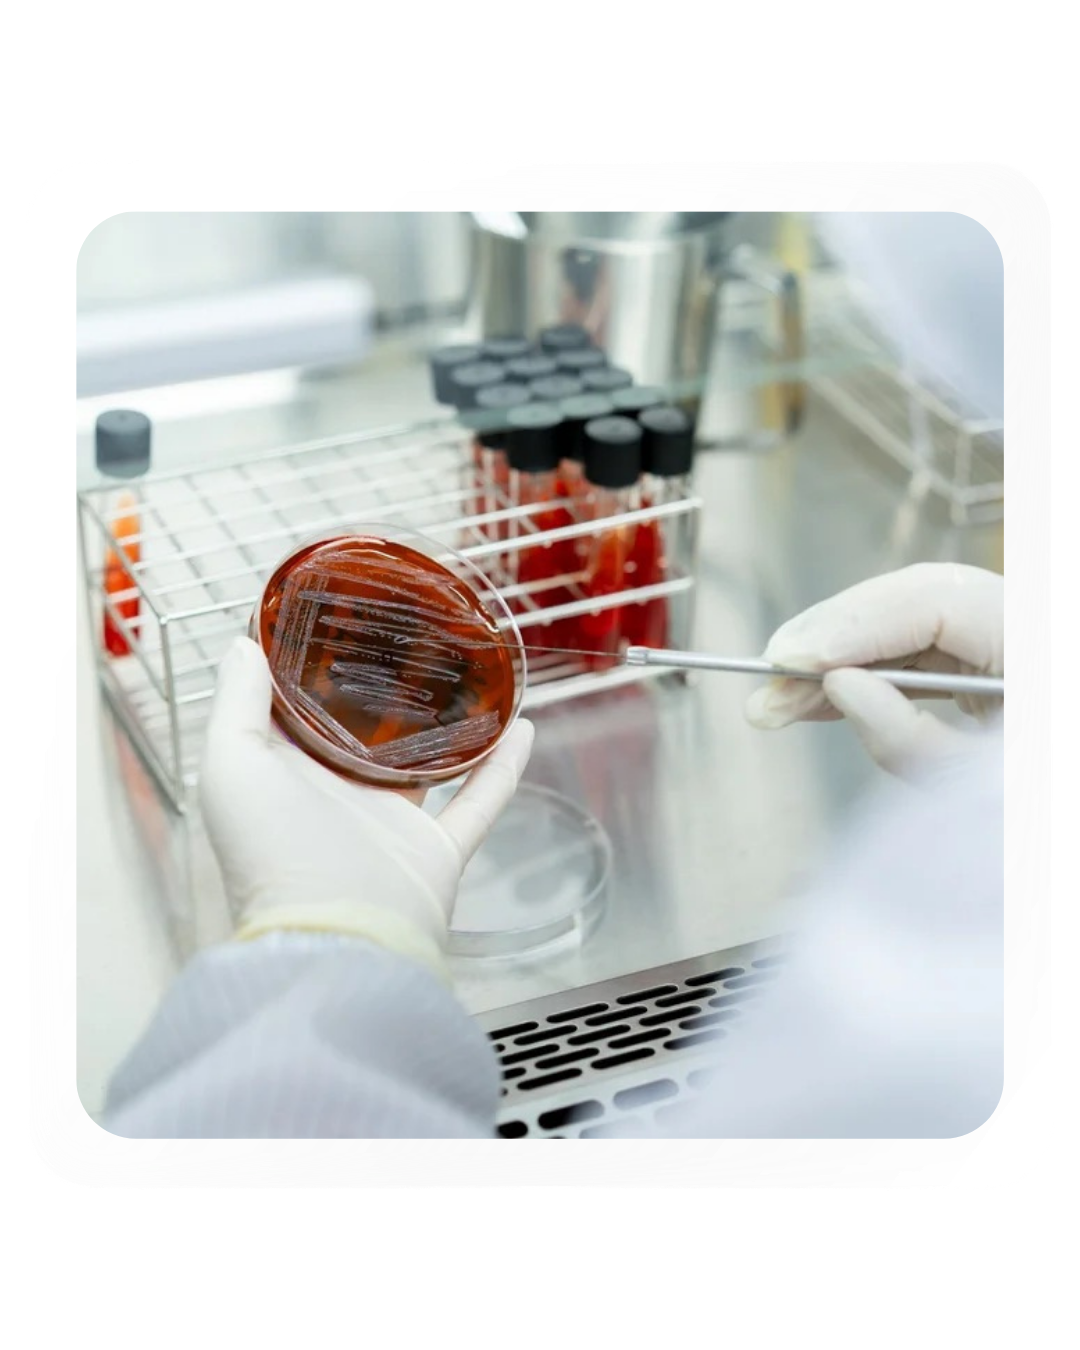

Asia’s Leading Plant Based Biotechnology Company
With the world edging towards aging society, we believe that the solution to global health lies in high quality plant-based biotechnology. Our team constantly researches the wide library of herbs and plants, with thousands years of tradition, to find the most effective compounds to cure various illnesses and improve health.
Thailand is often called the “Amazon of Asia” with a large pool of biodiversity, being centrally located with India to the West, China to the North East, and Indonesia to the South. With our advanced extraction, purification, and formulation technologies, we are able to bring the best of these products to the global markets.
We are fully vertically integrated from cultivation, to extraction, product formulation, and sales and distribution, with full certifications and licenses such as GACP, GMP, GMP PIC/S, ISO9001, ISO17025, amongst others. Our current product portfolio includes high potency extracts from cannabis (cannabinoids), and other plants (alkaloids).

Biotechnology Innovations
PACCAN’s Mitragynine Water Soluble
Through our proprietary extraction and processing method, we are excited to present our 80-85% mitragynine solution extracted from Thai kratom biomass, and is formulated to be water soluble.
Click on the image to be redirected to a full mitragynine extract page where you can find full information on COA, safety, and video presentation of the product.

Presenting our new compound positioned for cosmetic application: ZINC CBD
ZINC is widely used as a key ingredient in sun screen and sun block products as it presents a high Sun Protection Factor (SPF) level. SPFs with zinc oxide or titanium dioxide are considered mineral sunscreens. Currently, the FDA has concluded that zinc oxide and titanium dioxide are the only two sunscreen actives that are safe and effective.
At PACCAN we have infused CBD together with our ZINC isolate, creating a ground breaking proprietary compound that protects skin from sun exposure AND simultaneously nourishes the skin through CBD anti-inflamatory properties. ZINC CBD will help directly reduce damages from sunburn such as skin burn and skin peeling. We are ready to collaborate with cosmetic companies that want to develop these lines of innovative skin care products.




